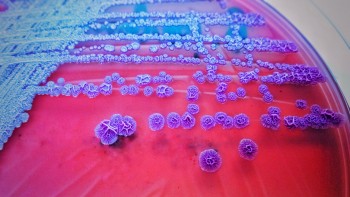
Xem hướng dẫn điều trị bệnh "ăn thịt người" Whitmore từ Bộ Y tế

Cứu sống bệnh nhân nguy kịch vì “vi khuẩn ăn thịt người”
Bệnh viện Ung bướu Thanh Hóa đã cứu sống một bệnh nhân 36 tuổi mắc bệnh Whitmore, một bệnh nhiễm trùng nguy hiểm với tỷ lệ tử vong cao.
| Bộ Y tế đưa ra khuyến cáo phòng chống bệnh Whitmore "Vi khuẩn ăn thịt người" có lây không? Người đàn ông suýt mất chân do vi khuẩn ăn thịt người tấn công |
Mới đây, Bệnh viện Ung bướu Thanh Hóa đã tiếp nhận một nam bệnh nhân 36 tuổi (không có bệnh lý nền) nhập viện với tình trạng tổn thương sưng nề, hoại tử, chảy dịch mủ, sùi loét nham nhở ở vùng bẹn trái, gây đau nhức và hạn chế vận động chân trái.
Theo bệnh sử, khoảng một tháng trước, bệnh nhân xuất hiện khối tổn thương sùi loét tại vùng bẹn trái, ngày càng to và kèm theo sốt kéo dài. Bệnh nhân đã được điều trị tại bệnh viện tuyến huyện nhưng không thuyên giảm, sau đó được chuyển lên Bệnh viện Ung bướu Thanh Hóa.
 |
| Các bác sĩ điều trị cho nam bệnh nhân nhiễm "vi khuẩn ăn thịt" (Ảnh: Tô Hà). |
Khi nhập viện, tình trạng tổn thương của bệnh nhân bao gồm sưng nề, hoại tử, chảy dịch mủ, sùi loét nham nhở ở vùng bẹn trái, khiến chân trái đau nhức và vận động khó khăn. Bệnh nhân được cách ly tại phòng riêng và tiến hành các xét nghiệm cần thiết. Kết quả cấy máu xác định bệnh nhân nhiễm khuẩn huyết do vi khuẩn Burkholderia pseudomallei, với nhiều ổ nhiễm khuẩn khu trú dạng hoại tử, loét và chảy dịch tại vùng bẹn trái.
Sau hơn hai tuần điều trị, các tổn thương dần khô, vết sùi loét liền sẹo tốt, không còn rò dịch hay hoại tử. Chiều 31/3, bệnh nhân được xuất viện trong trạng thái tỉnh táo, không sốt, hô hấp và tuần hoàn ổn định, vết mổ đã liền sẹo.
Theo các bác sĩ, bệnh Whitmore (Melioidosis) là bệnh truyền nhiễm nguy hiểm ở người và động vật do vi khuẩn Burkholderia pseudomallei gây ra. Bệnh có biểu hiện lâm sàng đa dạng, khó chẩn đoán và có tỷ lệ tử vong cao, đặc biệt trong các trường hợp viêm phổi nặng, nhiễm trùng huyết và sốc nhiễm trùng.
 |
| Tổn thương loét hoại tử mô, cơ vùng bẹn trái trước điều trị đa kháng sinh. Ảnh BVCC |
Bệnh lây truyền chủ yếu qua tiếp xúc với đất hoặc nước nhiễm khuẩn, đặc biệt qua các vết trầy xước ngoài da. Những người có hệ miễn dịch suy giảm hoặc mắc các bệnh lý nền như đái tháo đường, nghiện rượu, bệnh gan, thận, phổi mạn tính có nguy cơ cao mắc bệnh.
Hiện nay, chưa có vaccine phòng bệnh Whitmore. Khi nghi ngờ nhiễm bệnh, cần đến cơ sở y tế chuyên khoa để được tư vấn và điều trị kịp thời.
Để phòng bệnh, người dân cần chú ý giữ vệ sinh cá nhân, thường xuyên rửa tay bằng xà phòng và nước sạch, ăn chín, uống sôi, đảm bảo vệ sinh an toàn thực phẩm. Hạn chế tiếp xúc trực tiếp với đất và nước bẩn, đặc biệt tại các khu vực bị ô nhiễm nặng. Tránh tắm gội, bơi lội ở ao, hồ, sông tại hoặc gần nơi ô nhiễm. Đối với những người thường xuyên làm việc với đất và nước bẩn, cần sử dụng đồ bảo hộ lao động như giày, ủng, găng tay để giảm nguy cơ mắc bệnh.
Xem hướng dẫn điều trị bệnh "ăn thịt người" Whitmore từ Bộ Y tế Xem hướng dẫn điều trị bệnh "ăn thịt người" Whitmore từ Bộ Y tế |
 Đắk Nông xuất hiện trường hợp đầu tiên mắc bệnh vi khuẩn "ăn thịt người" Đắk Nông xuất hiện trường hợp đầu tiên mắc bệnh vi khuẩn "ăn thịt người" |
 Cách phòng bệnh Whitmore khi chưa có vaccine Cách phòng bệnh Whitmore khi chưa có vaccine |




























